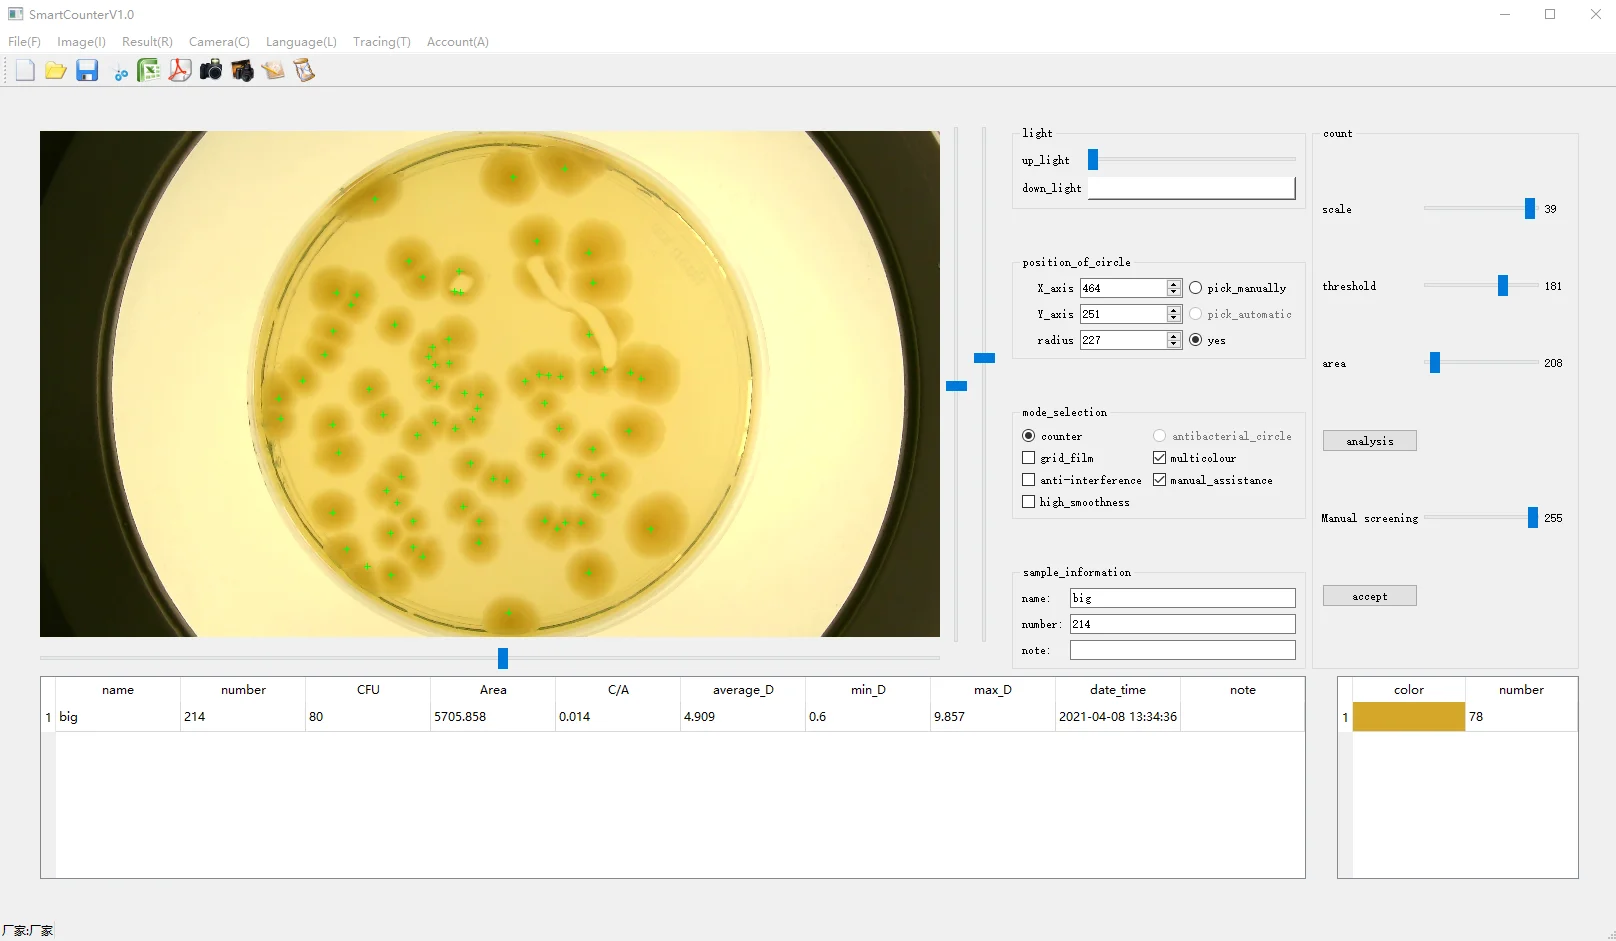

Электронный счетчик семян, цифровой автоматический счетчик семян
График изменения цены & курс обмена валют
Пользователи также просматривали

$88.96
J144 свадебное платье, новинка 2024, для невесты, выходное женское платье, тюль, белый атлас
aliexpress.ru
$17.82
Передача параметров 36 В, 72 в, АБС-пластик, электрический велосипед, высокое качество пробега, показывает мощность пробега 1,7 м
aliexpress.ru
$57.77
Плюшевый ковер для спальни, домашняя спальня, однотонные плюшевые ковры, прикроватный напольный коврик
aliexpress.ru
$2,712.23
0811402080 DREBE6X-1X/175MG24K31A 1M немецкий Rexroth REXROTH пропорциональный клапан
aliexpress.ru
$7.03
Гобелен Sisu в состаренном стиле с финским флагом, настенное украшение, эстетическое домашнее украшение
aliexpress.ru
$19.54
Bruce Lee Chinese Kungfu Posters Multi Pictures Canvas Wall Art Home Decor Paintings for Living Room Bedroom Decorations
aliexpress.com
$26.14
Кроссовки мужские легкие на шнуровке, Повседневная Удобная обувь для ходьбы, дышащие, большие размеры 50
aliexpress.ru
$24.80
Slim Fit Long Sweater Coat Fashion Trends Coat Green Cardigan Sweater Men Cardigan Long Autumn Streetwear Coat
aliexpress.com
$4.99
Rotating Dirt Blaster Turbo Nozzle With 1/4" Quick Release Plug Connector 035 for High Pressure Car Washers
aliexpress.com
$3.64
Metal Cutting Dies Japanese Dharma Kimono Lucky Cat Stencil Diy Scrapbooking Photo Album Decorative Embossing Paper Card Craft
aliexpress.com
$44.90
Gioio Brand Sports Causal lady Shoes High Quality breathe Sewing Sky Blue Running Walking Mixed Colors Shoes Jogging Women Shoe
aliexpress.com
$24.63
High quality Gold Floral Autumn Mens Silk Shirts Square Collar Male Casual Satin Long Sleeve Silk Shirts CC-006
aliexpress.com
$2.17
Children's Swimwear Sport Summer Kids Baby Girls Floral Two Pieces Swimwear Swimsuit Bikini Bathing Outfits Suits Beachwear
aliexpress.com
$0.55
300pcs Round Plastic Head Steel Point Push Pins Map Thumb Tacks Pin Office School Supplies
aliexpress.com
$13.16
Universal 8 10mm motorcycle Rearview mirrors Scooter chrome round Side mirror For Peugeot Django150i kisbee100 Trend Speedfight
aliexpress.com
$30.00
Snow boots female 2019 winter new fashion increased women's shoes plus velvet socks thick platform wool shoes boots
aliexpress.com
$9.99
New Maternity Leggings Adjustable High Waist Elastic leggings Pregnancy Trousers Polainas Leggings For Pregnant Women spring
aliexpress.com
$38.75
classique woman designer sandals flip flops for women stylish slipper classics sandal slipper, Black
dhgate.com
$24.66
women's two piece pants zanzea summer women short sets 2pcs suit casual loose tracksuit oversize vintage printed sleeve blouse matching, White
dhgate.com
$79.50
black hooded warm down coat long jacket winter loose jackets female overcoat thick parkas lady outwears 210510
dhgate.com
$47.21
bag women's new fashion versatile cross-body bag high-end texture one-shoulder small square bag trend
dhgate.com
$47.70
summer french hepburn style contrasting short sleeved doll neck with waistband for slimming effect split back wrap buttocks dress elegant lo, Black;gray
dhgate.com
$14.33
salon health & beauty1box approx 50pcs nail flower wood pulp sheet animal floral alphabet mixed jewelry patch for 3d art decorations bo2w1 d, Silver;gold
dhgate.com
$3.48
anti lost band kid child safety harness anti lost strap wrist leash walking 15m outdoor parent baby leash rope wristband belt ljj6202404
dhgate.com
$96.88
speed cross 3 cs outdoor mens running hiking shoes speedcross iii black green trainers men sports sneakers scarpe zapa2368779
dhgate.com
$21.36
blankets & swaddling muslin bamboo cotton gauze wrap born baby receving blanket solid color children bath towel bandage bag beddings
dhgate.com
$0.10
Free Shipping 1 Sample OK New Craft FLOVEME Custom Mini tws Earbuds 5.0 Wireless Headphone Earphones In ear Wireless Earphones
alibaba.com
$32.82
casual dresses fashion solid o neck long sleeve drawstring bandage mini dress women 2021 autumn winter ladies wrap hip bodycon, Black;gray
dhgate.com
$125.73
pendant lamps botimi modern lights for dining kitchen lampadario vintage gray metal hanging lamp restaurant luminaria light fixture
dhgate.com
$157.38
video door phones security hip 7" hands-videophone with camera home office intercom smart bell phone
dhgate.com
$20.30
Fashion-Hip Hip Streetwear Men Camouflage Joggers Pants 2021 Ribbons Cotton Cargo Pant Trousers Elastic Waist Harem Men, Champagne
dhgate.com
$4.79
Wholesale 35 Colors Mashed Potato Eyeshadow High Pigment Earth Tone Eye Shadow Private Label Eyeshadow Palette Manufacturers
alibaba.com
$21.06
4 x Heavy Duty 75mm Swivel Castor Wheels Trolley Furniture Caster with Brakes - Load Capacity 100kg Per Wheel (Set of 2 x Swivel
aliexpress.com
$77.81
Trust Evo Silent Wireless Keyboard with mouse ES, Standard, Wireless, RF Wireless, QWERTY, Black, Mouse included
aliexpress.com
$1.29
18 Inch Doll Clothes-Cute Bikini Suit for My Little Baby-18"/Life/Generation Doll Accessories Toys fit Girl welcome Gift
aliexpress.com
$12.39
Voltage Monitoring Relay GRV8-04 3-Phase Voltage Monitoring Relay Phase Sequence Phase Failure Protection M460
aliexpress.com
$12.87
3D-принтер Artillery Sidewinder X3X4, шаговый двигатель с вертикальной осью, бесшумный, быстрый
aliexpress.ru